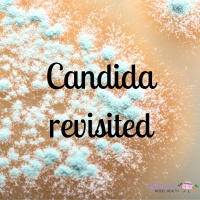
#227 Candida Revisited

Sinopsis
Biohacker, Personal trainer, Pilates instructor and Nutritional Therapist, specializing in orthomolecular nutrition, long term weight loss, anabolic growth, brain health and more ---- total human health optimization xo
Episodios
-
#244 Becoming Your Own Poop Detective - what is your poop telling you?
14/11/2022 Duración: 14minDo you look at your poop? If not, you should! The shape, color, and overall appearance of your stool can be very revealing to you what might be going on with your health. This can be helpful if you have kids too. So, in this podcast episode we will be going through stool and what it might be trying to tell you. Hopefully this helps you become your own poop detective (and your families too). As always, please share with anyone you feel might benefit from this information, and please subscribe to the podcast if you haven't already. ;) ;)
-
#243 How does low fiber effect bile, immunity, weight, & vitality?
11/11/2022 Duración: 35minI bet you didn't know that fiber plays a very important role in many of the body's processes, including preventing gallstones, maintaining good skin health, and even brain health and performance. Many of us have always been aware of the notion that "fiber is good", but why? Well hopefully this new episode helps you learn and encourages you to include fiber into your days more regularly. As always, please like, share and subscribe. Helping one can help many. ;)
-
#242 Understanding binge & overeating with Dr Glenn Livingston
28/10/2022 Duración: 01h01minToday I had the immense pleasure of speaking to Dr Glenn Livingston for an hour+ on binge eating, emotional eating, creating bright lines and control, and more. I hope you enjoy it!! Please comment and let me know. :) Glenn is a veteran psychologist, author of bestselling books "never binge again" and "101 best food rules" . He is also Co-Founder of Never Ever Again, Inc., a company which specializes in helping people stop binge eating and overeating, lose weight, and learn how to think like a permanently slimmer person on the diet and lifestyle of their choice. He has spent several decades researching the nature of binging and overeating with his own patients, which included a self funded research program with more than 40,000 participants. You can find all about Dr Glenn Livingston and his work below and be sure to grab your FREE BOOK! Web - https://www.neverbingeagain.com/ Facebook - https://www.facebook.com/NeverBingeAg... IG - https://www.instagram.com/livingstong... References made by Chemaine; Ap
-
#241 Thyroid Health - Influencers and considerations
17/10/2022 Duración: 28minIn this weeks podcast episode we are looking at thyroid health, how the hormones are produced, what influences thyroid health and other considerations, including nutrients and practices that can help with thyroid health. If you found this episode helpful, you might like to go back and listen to the 3 thyroid episodes I did in the early days of this podcast. ;) As always, please like, share and subscribe to the podcast if you haven't already. I appreciate you all!
-
#240 The Importance of Detoxification with Wendy Myers ND
06/10/2022 Duración: 53minLast week I had an in depth talk with the one and only Wendy Myers ND on the importance of detoxification and why you need to prioritize it in your days. Detoxification plays a HUGE role in your health, including immunity, thyroid, gut health, adrenal health, mentals health, and even your spiritual/energetic health. *Wendy did have some internet issues at the 20.49 minute mark and the 24 minute mark, but she does come back and I fill in the gaps. These gaps were edited out of the audio version. Wendy is a Naturopathic Doctor, Functional diagnostic practitioner, and hair mineral analysis practitioner. To find out more about Wendy, you can do so here; Web - https://myersdetox.com/ Facebook - https://www.facebook.com/MyersDetox/ Instagram - https://www.instagram.com/myersdetox/?hl=en If you haven't liked or subscribed to my podcast already, please do! And remember, sharing is caring. ;)
-
#239 Living an optimal life with herpes, with Alexandra Harbushka
30/09/2022 Duración: 52min#herpes #herpesawareness #herpesvirus In this conversation Alexandra and myself discuss life with herpes. The types of herpes, symptoms, getting a diagnosis, not letting herpes define who you are, and more! Alexandra is founder of "Live with Herpes", where she provides community, support, and valuable information for people living with herpes. She is an advocate for not letting a herpes destroy or determine your life. Enjoy and please leave a comment and let us know what you think! :) Find more about Alexandra here; Web https://www.lifewithherpes.com/ IG https://www.instagram.com/lifewithherpes/?hl=en Podcast https://podcasts.apple.com/ca/podcast/life-with-herpes/id1247691746 Please share with anyone you feel might benefit from this, and if you haven't subscribed already... well you know the drill. ;)
-
#238 TCM, Trauma, Kidney imbalances, Shadow work, and more with Winnie Wang
28/09/2022 Duración: 01h03minToday I spent some time chatting with Winnie Wang and Ill I can say is WOW! (Check out the part where I welled up). Winnie is a Traditional Chinese medicine practitioner out of Pasadena. She specializes in trauma, energy healing, shadow work and more. Winnie also has a book out not titled "Honoring darkness" where she helps guide you through the darkest parts of you. For more on Winnie you can find her @ Web https://mindfulhealingheart.com/ Facebook https://www.facebook.com/MindfulHeali... Instagram https://www.instagram.com/mindfulheal... You can find Winnies book in most bookstores or here; https://amzn.to/3xK9giC As always, please share with anyone you feel may benefit from this, sharing is caring. Can give us a like if you feel its deserved. ;)
-
#237 Hormones, Adrenals, Toxins, and more with Dr Koz
21/09/2022 Duración: 01h08minToday I had the pleasure to pick Dr Koz' brain on hormones, the adrenals, toxins, and even libido, and gut health. We also wrapped up with how he came up with the funcy names for his books (pun intended ;) ). *there is a freeze frame for a few mins mid video but it should be fixed in the audio* Dr Koz' new book "Get the func out. Balance your hormones and Detox", comes out in October and can be found on Amazon and larger book stores. Check out our chat to find out more! You will also find the video version of this conversation over on YouTube. You can also find Dr Koz at; web: Doc-Koz.com fb: doctorkoz insta: @doc_koz
-
#236 EMF, dirty electricity, grounding, and more, with Justin Frandson
13/09/2022 Duración: 01h01minThis week I had a very interesting chat with Justin Frandson on how EMFs are effecting our current and future health, our brains, our childrens health, and how we can protect ourselves. We also touched on some controversial topics, that I think will be interesting to you too! Justin is a well respected Athleticism performance coach and founder of EMF rocks. He has been in the health industry for over three decades now, and we hope you enjoy this conversation. You can find out more about EMF Rocks here; https://emfrocks.com/products/deep-sl... And Justins Athleticism work here; https://athleticism.com/ The Stetzer meter that was mentioned in the conversation here; https://www.stetzerelectric.com/
-
#235 Colostrum, gut health, mood help, anti-aging, and more with Angela Walker
31/08/2022 Duración: 01h03minAngela Walker is the Content creator for Sovereign Laboratories, who are one leading the way when it comes to colostrum. Angela and myself had a great fun chat about colostrum, its benefits, the importance of gut health, what Sovereign laboratories are doing in the world of colostrum, and so much more. We hope you enjoy this information! And I apologize for the few audio issues on my part (I thought I had them fixed eek). If you would like to find out more about Sovereign Laboratories and their supporting research, you can do so here; https://www.sovereignlaboratories.com/ https://www.sovereignlaboratories.com... Studies mentioned; https://clinicaltrials.gov/ct2/show/N... https://link.springer.com/article/10.... https://www.ncbi.nlm.nih.gov/pmc/arti... http://www.foodandnutritionjournal.or...
-
#234 Understanding Creatine
26/08/2022 Duración: 27minBelieve it or not, I actually do get many questions about creatine, from women, men and teenagers. So hopefully I answer all your questions about creatine, its benefits, and dosing, in this new podcast episode. If you haven't subscribed to my podcasts already, please do! And of course share with anyone you feel would benefit from this information. :)
-
#233 Human growth hormone, growth factors, sex hormones & more, with Dustin Baker
19/08/2022 Duración: 01h52s*There are some mic issues at the beginning but it improves after a few minutes*. Join Dustin Baker, founding president of Bioprotein Technology and myself, as we take a deep dive on human growth hormone, growth factors and so much more, for optimizing your self and life. Also healing, regeneration, #antiaging , inflammation, fat loss and more. Could human growth hormone be the missing piece of your puzzle to have you "feeling like yourself" again? Let us know what you think! If you would like to find out more about Dustin and his products, you can do so here - https://bioproteintech.com/ Also some references on benefits of HGH and IGF here; https://bioproteintech.com/benefits#o... https://www.health.harvard.edu/diseas... https://www.ncbi.nlm.nih.gov/pmc/arti... https://www.ncbi.nlm.nih.gov/pmc/arti... https://www.ncbi.nlm.nih.gov/pmc/arti... https://health.selfdecode.com/blog/th... As always, sharing is caring! Please share with anyone you think might find this information helpful or interesting. :)
-
#232 The wonderous world of Serrapeptase for inflammation, blood clots, infections & more.
17/08/2022 Duración: 31minI know several of my clients and followers are going to be super psyched to listen to this episode! My hope is that it helps you understand what exactly Serrapeptase is, how it might benefit you, and of course why I'm such a fan of it. I personally use Serrapeptase for my inflammation and gut health, and have done for years. Understanding how certain molecules work can help you understand if the might be a good fit for you or not. Please let me know if you have any questions! And please share with anyone you feel might benefit from this information.
-
#231 Everything monolaurin with Damon Sununtnasuk
11/08/2022 Duración: 52minIn this new episode, Damon Sununtnasuk and myself discuss everything "monolaurin". If you haven't heard of monolaurin before, your about to have to mind blow. The potential benefits of monolaurin for everything from Candida, Thyroid health, metabolism, hair health and more is outstanding. Damon is CEO and founder of Natural Cure Labs with a background in health and business. You can check out his website here; https://www.naturalcurelabs.com/ DISCOUNT CODE BELOW Sites and studies referenced in this video; https://www.naturalcurelabs.com/ https://www.monolaurinandmore.com/ https://pubmed.ncbi.nlm.nih.gov/32952... https://www.nature.com/articles/s4159... If you would like to check out Natural Cure Labs products, you can use the below link and discount code - MODELHEALTH for 10% off. https://www.naturalcurelabs.com/produ...
-
#230 Detoxification Broken Down
31/07/2022 Duración: 29minIn this new episode I break down the different phases of detoxification, and how to support detoxification. I get asked about "detoxing" all the time, and I want to remind everyone that the body is detoxing all day every day. We just want to make sure the process is optimized. So hopefully this episode helps you do that. As always, please share with anyone you feel might benefit from this information. :)
-
#229 Seasonal Allergies Support
28/07/2022 Duración: 17minSeasonal allergies are everywhere right now! But what is happening in your body, and are they natural alternatives to over the counter medications? In this episode I explain in an easy to understand way (I hope), what exactly is happening with seasonal allergies in your body and I give you 5 effective natural options to support your body and reduce symptoms. Check it out!
-
#228 Addressing The Itch (Candida & BV)
13/07/2022 Duración: 17minFollowing up on our last episode titled "Candida revisited", what do you do if you are experiencing that very unfun itch that can come with a Candida (and even bacterial vaginosis) overgrowth? Well here are some simple tips ... check them out! As always, please like, share and subscribe if you haven't already.
-
#227 Candida Revisited
13/07/2022 Duración: 30minIn this episode we are revisiting yeast overgrowth, or Candida. We go in depth on the signs, symptoms, causes, testing and the steps to take on addressing Candida. Please let me know if I can help you at all around this topic. As always, please like share and subscribe if you have not already. :)
-
#226 Time To Get Realistic -no More BS
30/06/2022 Duración: 14minTime for some REAL TALK... some people are not being realistic at all on what is required, and what they need to do, to attain the health and body they want. Most people put in a half @$$ effort... if this is you then this is an episode you NEED to listen to. Its for your own good! And please like, share and subscribe if you haven't already - that's also for your own good. ;)
-
#225 Circadian Rhythms & Fat Loss
30/06/2022 Duración: 32minYou may not think it but your circadian rhythm and the timing of your meals have a big influence on your metabolism and fat burning potential. Literally the timing of your meals could make or break your results. Take a listen to this newest podcast episode to find out what I mean. And please like, share and subscribe of you haven't already. ;)